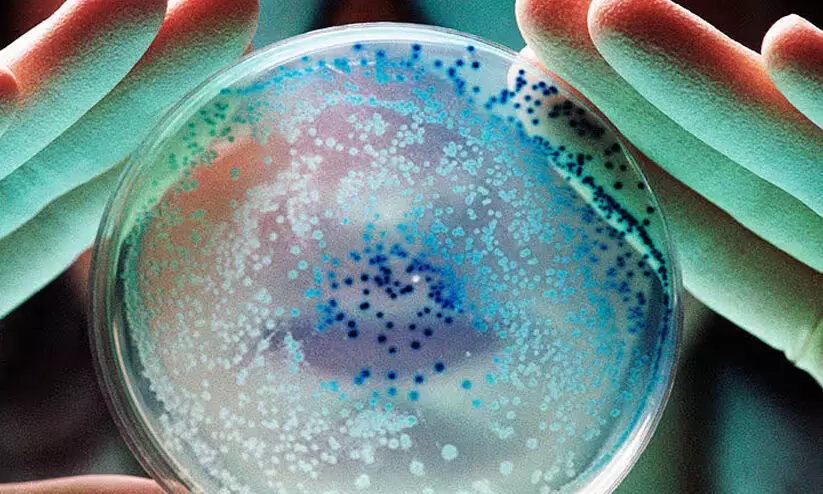
തലവടിയിലെ രഘുവിന്‍റെ മരണം കോളറയല്ല;   കുട്ടനാട്ടിൽ ആരോഗ്യവകുപ്പ്​ ജാഗ്രതനിർദേശം തുടരും

തലവടിയിലെ രഘുവിന്റെ മരണം കോളറയല്ല; കുട്ടനാട്ടിൽ ആരോഗ്യവകുപ്പ് ജാഗ്രതനിർദേശം തുടരും
text_fieldsആലപ്പുഴ: സ്വകാര്യആശുപത്രിയിൽ ഏഴുദിവസമായി ചികിത്സയിൽ കഴിഞ്ഞ 48കാരൻ രഘുവിന് കോളറയല്ലെന്ന് ആരോഗ്യവകുപ്പ്. നേരത്തെ നടത്തിയ രക്തസാമ്പിൾ പരിശോധനയിൽ വിബ്രിയോ കോളറയുടെ സാന്നിധ്യം കണ്ടെത്തിയിരുന്നു. വെള്ളിയാഴ്ച പുലർച്ചയാണ് ഇയാൾ മരണത്തിന് കീഴടങ്ങിയത്. ഇതിന് പിന്നാലെ വന്ന മലത്തിന്റെ പരിശോധനാഫലം നെഗറ്റിവായിരുന്നു. അതേസമയം, നേരത്തെ കുട്ടനാട്ടിലെ മുൻകാല സാഹചര്യങ്ങളും വരുന്ന മഴക്കാലവും കണക്കിലെടുത്ത് ജാഗ്രതനിർദേശം തുടരാനാണ് ആരോഗ്യവകുപ്പിന്റെ നിർദേശം. ലിവർ സിറോസിസടക്കം മറ്റ് രോഗങ്ങളാണ് പി.ജി. രഘുവിന്റെ മരണകാരണമെന്നാണ് വിലയിരുത്തൽ.
അതീവ ഗുരുതരാവസ്ഥിയിൽ ഏതാനും ദിവസമായി വെന്റിലേറ്ററിലായിരുന്നു. രണ്ടുദിവസംമുമ്പ് നടത്തിയ രക്തം കൾച്ചർ പരിശോധനയിലാണ് വിബ്രിയോ കോളറ സാന്നിധ്യം ആദ്യം കണ്ടെത്തിയത്. അത് നൂറുശതമാനം ഉറപ്പിക്കാനാണ് മലം പരിശോധിച്ചത്. ചികിത്സക്കിടെ രണ്ടുതവണ മലപരിശോധനയിൽ രോഗാണുവിനെ കണ്ടെത്താനായില്ല. മലത്തിൽ കോളറ അണുവിന്റെ സാന്നിധ്യം കണ്ടെത്തിയാൽ മാത്രമേ കോളറ സ്ഥിരീകരിക്കാൻ കഴിയൂ. ലോറി ഡ്രൈവറായി ജോലിനോക്കിയിരുന്ന രഘു കഴിഞ്ഞ രണ്ടാഴ്ചക്കിടെ നിരവധി സ്ഥലങ്ങളിലേക്ക് യാത്രകൾ നടത്തിയിരുന്നു. ഇതിനിടെ പുറത്തുനിന്നും വെള്ളവും ഭക്ഷണവും കഴിച്ചതിൽനിന്നാണ് രോഗബാധയുണ്ടായയെന്നാണ് സംശയം.
ഏറെക്കുറേ കോളറയാണെന്ന് ഉറപ്പിച്ചായിരുന്നു പ്രദേശത്ത് ആരോഗ്യവകുപ്പിന്റെ പ്രതിരോധ പ്രവർത്തനങ്ങൾ ഊർജിതമാക്കിയത്. ഇതിന് മുമ്പ് പലതവണ കോളറ സ്ഥിരീകരിച്ചതും മരണമുണ്ടായതും കുട്ടനാടാണ്. അതിനാൽ ഇക്കാര്യത്തിൽ കൂടുതൽ കരുതലും ശ്രദ്ധയുമുണ്ടായിരുന്നു. ശുദ്ധജലം കിട്ടാത്തതാണ് കുട്ടനാട്ടിലെ രോഗബാധക്ക് പ്രധാനകാരണം. 2013ലാണ് ഒടുവിൽ കോളറ പിടിപെട്ടത്. അന്ന് 10 പേർക്ക് രോഗബാധയുണ്ടായി. അതിനുമുമ്പ് ഒട്ടേറെ മരണവുമുണ്ടായി.
2002ൽ കുട്ടനാട്ടിൽ കോളറ പടർന്നപ്പോൾ ഒട്ടേറേപേർക്ക് ജീവൻപോലും നഷ്ടമായി. 2009-ൽ കൈനകരിയിൽ രണ്ടുപേർ മരിച്ചു. 20 പേർക്ക് രോഗം പിടിപെട്ടു. 2012ലും 2013ലും കോളറ കുട്ടനാടിനെ വിടാതെ പിന്തുടർന്നു. പാചകത്തിന് ആറ്റിലെയും കായലിലെയും വെള്ളം ഉപയോഗിക്കുന്നതായിരുന്നു കോളറ ഉൾപ്പെടെയുള്ള വയറിളക്കരോഗങ്ങൾ വ്യാപകമാകാൻ കാരണമായത്.
Don't miss the exclusive news, Stay updated
Subscribe to our Newsletter
By subscribing you agree to our Terms & Conditions.